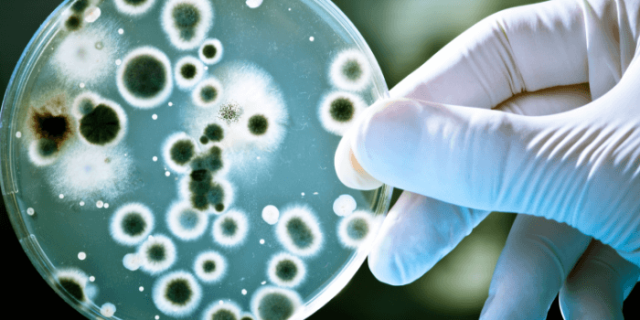

برنامه زمانبندی ثبت نام جهت اخذ گواهی نامه تایید صلاحیت بر اساس استاندارد 17025
برنامه زمانبندی ثبت نام جهت اخذ گواهی نامه تایید صلاحیت بر اساس استاندارد 17025 بنابر الزامات سازمان ملی استاندارد ایران،
مقادیر کاربردی آزمون F
مقادیر کاربردی آزمون F جهت بررسی نتایج آزمون های f tets می تواند از مقادیر بحرانی آزمون F در سطح
عدم قطعیت شمارش میکروبیولوژیکی
مثالهای ارائهشده برای نشان دادن راههایی برای اجرای سیاستهای A2LA برای تخمین عدم قطعیت اندازهگیری برای روشهایی است که از
کتاب مونتگومری
داگلاس سی مونتگومری، استاد مهندسی صنایع و آمار و استاد مهندسی بنیاد دانشگاه ایالتی آریزونا است. ایشان مدارک کارشناسی، کارشناسی
راهنمای استفاده از نرم افزار QMSys GUM
آﺷﻨﺎﯾﯽ ﺑﺎ نرم افزار QMSys GUM محصولات نرم افزاریQMSys GUM ابزارهای جامعی برای تجزیه و تحلیل عدم قطعیت اندازه گیری
راهنمای استفاده از نرم افزار مینی تب
راهنمای استفاده از نرم افزار مینی تب شماره صفحهعنوانردیف3Minitab Introductionآﺷﻨﺎﯾﯽ ﺑﺎ ﻣﺤﯿﻂ مینی تب117Normality testبررسی نرمال بودن توزیع نتایج آزمون218statistical
آنالیز سیستم های اندازه گیری
آنالیز سیستم های اندازه گیری دادههای اندازهگیری بیشتر از گذشته و به روشهای بیشتری استفاده میشوند. به عنوان مثال، تصمیم
مدیریت کیفیت در صنعت خودرو
مدیریت کیفیت در صنعت خودرو مدیریت کیفیت در صنعت خودرو و قابلیت فرآیندهای اندازه گیری- استانداردها و دستورالعملهای مدیریت کیفیت

با درود و احترام؛ جناب مهندس در مورد mpu و نحوه یافتن ضریب آن هم (f) لطف می کنید مطلب…
This is a wonderful article, Given so much info in it, These type of articles keeps the users interest in…